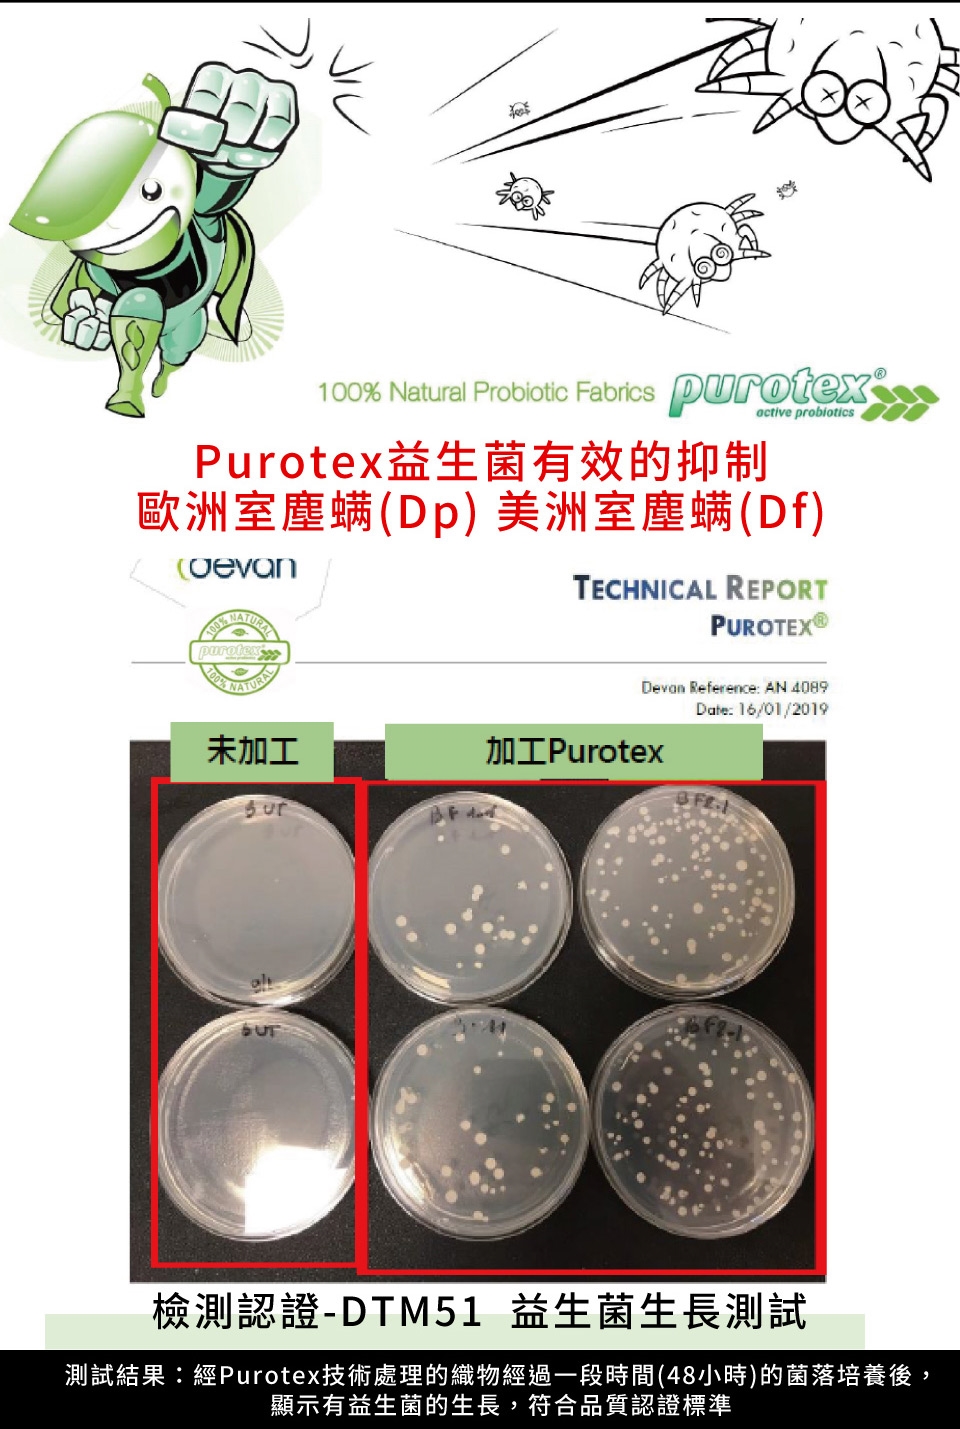

商品詳細介紹

使用方法說明
洗滌方式:不可水洗、專業乾洗、不可漂白、不可熨燙、平攤晾乾
注意事項
※ 顏色:如圖,網頁產品因拍攝關係,與實品略有差異,實品顏色更佳 。產品圖僅供參考,不含拍攝道具,實際內容以包裝規格為主。
※ 鑑賞期說明:鑑賞期非試用期,本商品屬於個人衛生性用品,如經拆封、使用、下水洗滌、或拆解以致缺乏完整性,即會無法銷售。拆封使用前請審慎考量;商品若欲辦理退款依法需先恢復商品原狀,否則需支付恢復商品原狀之費用方得辦理退款。(新品瑕疵除外)
注意事項:
1. 個人衛生用品,如經拆封使用、下水洗滌或拆解以致缺乏完整性及失去再販售價值時,恕不接受退換貨。
2. 商品製作時,布料為大量裁剪,故花紋因裁剪可能會不同位置(指布料位置會與圖片不同)
3. 若有下列情況發生,將無法受理退換貨或視損毀程度折扣退款金額。
4. 退換貨時應保留贈品及附件完整(含主商品紙箱、包裝袋與贈品包裝袋、紙箱,如有遺失部分,需酌收費用)。
5. 商品內外的乾淨、無異味、髒污及損壞。
6. 配送範圍:限台灣本島,實因特殊地型限制、偏遠鄉鎮、山區無法送貨時,本公司保有出貨與否權利。
如欲知詳細區域,請來電客服詢問,不便之處,敬請見諒!
7. 偏遠地區將由專人確定是否需額外加收運費(含退貨),並電通知出貨與否。
※ 鑑賞期說明:鑑賞期非試用期,本商品屬於個人衛生性用品,如經拆封、使用、下水洗滌、或拆解以致缺乏完整性,即會無法銷售。拆封使用前請審慎考量;商品若欲辦理退款依法需先恢復商品原狀,否則需支付恢復商品原狀之費用方得辦理退款。(新品瑕疵除外)
注意事項:
1. 個人衛生用品,如經拆封使用、下水洗滌或拆解以致缺乏完整性及失去再販售價值時,恕不接受退換貨。
2. 商品製作時,布料為大量裁剪,故花紋因裁剪可能會不同位置(指布料位置會與圖片不同)
3. 若有下列情況發生,將無法受理退換貨或視損毀程度折扣退款金額。
4. 退換貨時應保留贈品及附件完整(含主商品紙箱、包裝袋與贈品包裝袋、紙箱,如有遺失部分,需酌收費用)。
5. 商品內外的乾淨、無異味、髒污及損壞。
6. 配送範圍:限台灣本島,實因特殊地型限制、偏遠鄉鎮、山區無法送貨時,本公司保有出貨與否權利。
如欲知詳細區域,請來電客服詢問,不便之處,敬請見諒!
7. 偏遠地區將由專人確定是否需額外加收運費(含退貨),並電通知出貨與否。